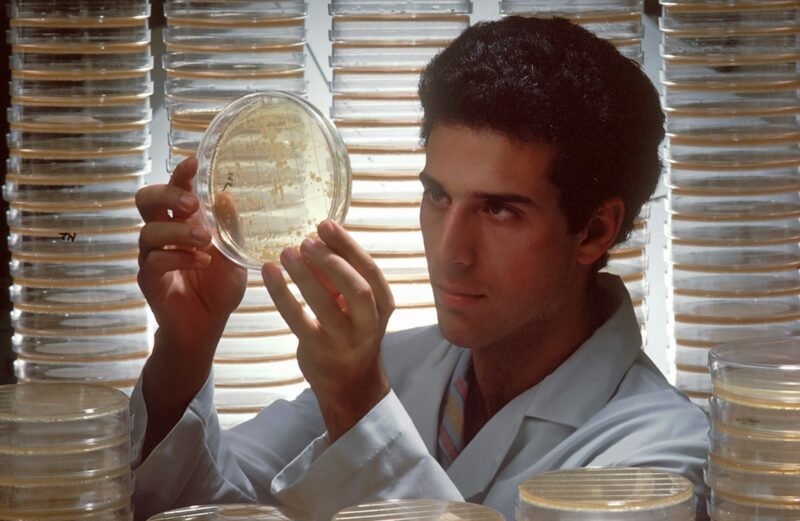
a man in a lab coat holding up a plate

Water is life, but in Kashmir, it is increasingly becoming a source of disease. In 2024 alone, we saw over 80,000 cases of waterborne diseases reported in the Valley. From Anantnag to Sopore, outbreaks of Hepatitis A and Hepatitis E are becoming terrifyingly common. The “Yellow” Danger: Hepatitis We often think of Jaundice as a […]
The “Invisible” Exhaustion: Why 68% of Kashmiri Women Are Running on Empty
Look around your home. Look at your mother, your sister, your wife. Statistics tell us that nearly 7 out of 10 of them are suffering in silence. According to recent health data, the prevalence of Anemia among women in Jammu & Kashmir has hit an alarming 68.6%. This isn’t just a “medical stat”—it is a […]
The “Hamam Trap”: 3 Health Risks of the Kashmiri Winter Lifestyle
There is nothing quite like the comfort of a warm Hamam on a snowy day. We sit, we talk, we drink endless cups of Nun Chai, and we eat Harissa. It sounds cozy, but biologically, it is a metabolic trap. When our activity levels drop to near zero in winter, but our intake of salt […]
Fire in the Belly: When Your “Acidity” is Actually a Warning Sign
We Kashmiris love our food. The Wazwan, the Rista, the Tabak Maaz—it is part of our soul. But it is also true that Kashmir has one of the highest rates of Gastric (Stomach) Cancer in India. Is it the spice? Is it the meat? Actually, the biggest culprit might be a tiny bacteria called H. […]
The “Kashmir Syndrome”: 3 Silent Health Crises Hiding in Plain Sight
The “Kashmir Syndrome”: 3 Silent Health Crises Hiding in Plain Sight (And Why You Can’t Ignore Them) We Kashmiris are known for our resilience. We endure long winters, harsh terrains, and difficult times. But sometimes, that same resilience works against us. We have a habit of saying “Che kya karakh, ye chu bas takan” (What […]
“Red Rods” Under the Lens: Why the AFB Smear is Still the First Line of Defense
Introduction: The 100-Year-Old Test That Saves Lives In an era of DNA sequencing and molecular diagnostics, it seems almost archaic that one of the most important tests for Tuberculosis (TB) involves a microscope, a glass slide, and a splash of red dye. Yet, the Acid-Fast Bacilli (AFB) Smear remains the rapid-response engine of TB control […]
The “Dual-Threat” Marker: What Beta-2 Microglobulin Reveals About Cancer and Kidneys
Introduction: The Protein That Never Sleeps In the world of oncology and nephrology, there is a protein that acts as a silent speedometer for cellular activity: Beta-2 Microglobulin (B2M). Unlike routine cholesterol or sugar tests, B2M is not a standard screening tool for the general public. It is a specialized “tumor marker” and “kidney stress […]
Unexplained Bruising? The “Coagulation Cascade” and What Your APTT Test Reveals
Introduction: The Delicate Balance of Blood Human blood is a biological marvel. It must remain liquid enough to flow through miles of microscopic capillaries, yet solid enough to clot instantly the moment a vessel is breached. This balance is maintained by a complex domino effect known as the Coagulation Cascade. When this system fails, the […]
The End of “Guesswork” Medicine: Why Culture & Sensitivity Testing is Non-Negotiable
Introduction: The Silent Crisis of Empirical Prescribing For decades, the standard medical approach to common infections—Urinary Tract Infections (UTIs), wound infections, or persistent fevers—was “empirical prescribing.” A doctor would look at the symptoms, guess the likely bacteria, and prescribe a broad-spectrum antibiotic. This “fire-and-forget” method saved time, but it has contributed to one of the […]
Unlocking the Mystery of “Fever of Unknown Origin” (FUO)
Introduction: When the Thermometer isn’t Enough One of the most frustrating diagnoses in clinical medicine is “Viral Fever” or “FUO” (Fever of Unknown Origin). Patients frequently present with nonspecific symptoms—high fever, joint pain, night sweats, and fatigue—and often bounce between providers who prescribe broad-spectrum antibiotics or painkillers without a definitive diagnosis. The reality is that […]